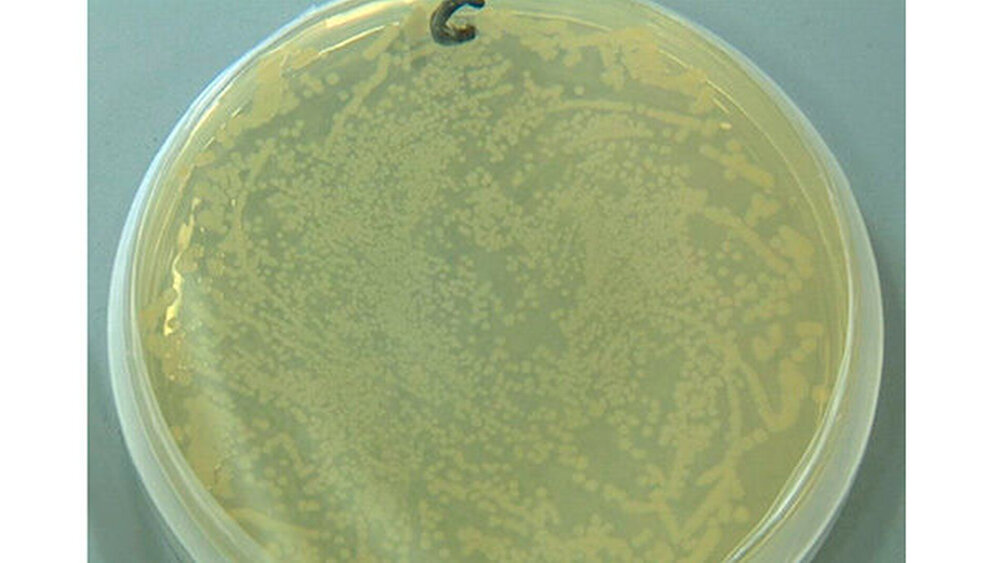
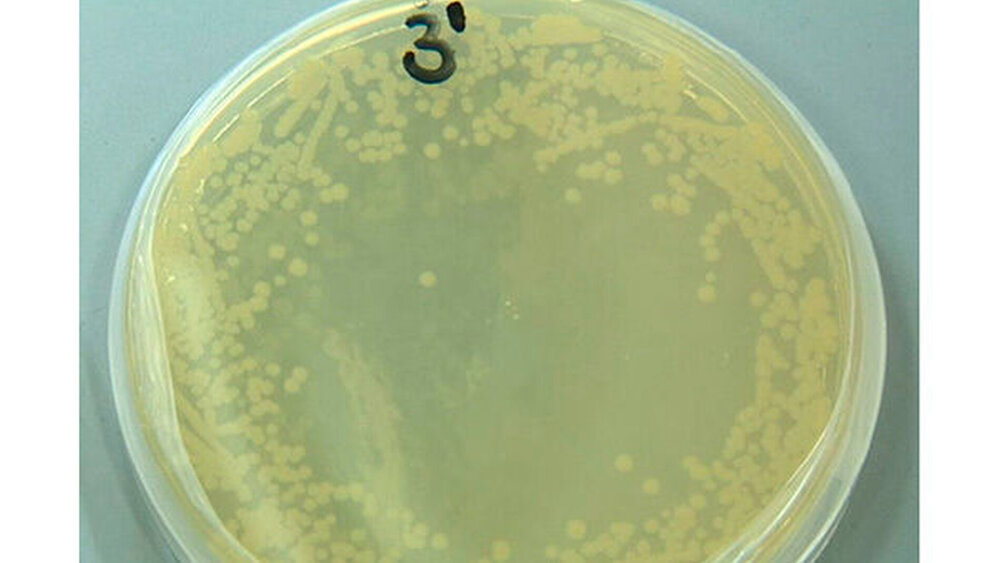

Kaltes Plasma gegen Karies?
Während heißes physikalisches Plasma bereits seit vielen Jahren in der Medizin verwendet wird, ist kaltes physikalisches Plasma ein sogenanntes Niedrigtemperaturplasma, das entsteht, wenn Gas Energie zugeführt wird. Für die MKG-Chirurgie in Klinik und Praxis ist die innovative Anwendung von kaltem Plasma bei Wundheilungsstörungen sowie als Bakterien- und Keimkiller bereits etabliert.
Kaltes Plasma gegen Krebs und für heile Haut
Erstmals fand jetzt ein Forschungsteam heraus, dass das neue Hightech-Verfahren auch für die Krebstherapie erstaunliche Perspektiven eröffnet. Im Nationalen Zentrum für Plasmamedizin beschäftigen sich Wissenschaftler wie einer der Referenten der diesjährigen Pressekonferenz der Deutschen Gesellschaft für Mund-, Kiefer- und Gesichtschirurgie (DGMKG), Prof. Dr. Dr. Hans-Robert Metelmann, MKG-Chirurg und Vorstandsvorsitzender des Zentrums, interdisziplinär mit der genauen Wirkung auf maligne Tumorzellen.
Vor einem regelmäßigen klinischen Einsatz, beispielsweise gegen Mundhöhlenkrebs, bleibt noch viel Forschungsarbeit zu leisten. Wie in der Krebstherapie könnte kaltes Plasma aber auch in der ästhetischen Medizin über seine bloße Rolle als unterstützende Technologie hinauswachsen. Hautgewebe, das sich wie von selbst glättet, strafft und reinigt? Zu diesem zukunftsweisenden Ergebnis führten erste Untersuchungen unter Laborbedingungen. Deutschland ist neben Japan und den USA Spitzenreiter in der Entwicklung und Umsetzung dieser innovativen Verfahren.
Noch Zukunftsmusik: Plasma gegen Karies
Weiter entwickelt, aber immer noch im vorklinischen Stadium, ist die Anwendung von Plasma gegen Zahnkaries. Diese Erkrankung wird ebenfalls durch Keime ausgelöst, die sich mit physikalischem Plasma deaktivieren beziehungsweise abtöten lassen. Es bleibt zu klären, ob die Methode auf Mineral reichem Zahnschmelz ebenso gut wirkt wie auf Hautoberflächen und ob sie hilft, Zahnkaries vorzubeugen oder vielleicht sogar kariöse Läsionen zu sanieren.
Artikel nicht gefunden id_extern: typo3-import-article-483
<interactive-element xmlns:ns3="http://www.w3.org/1999/xlink" ns3:href="censhare:///service/assets/asset/id/" ns3:role="censhare:///service/masterdata/asset_rel_typedef;key=actual."/>